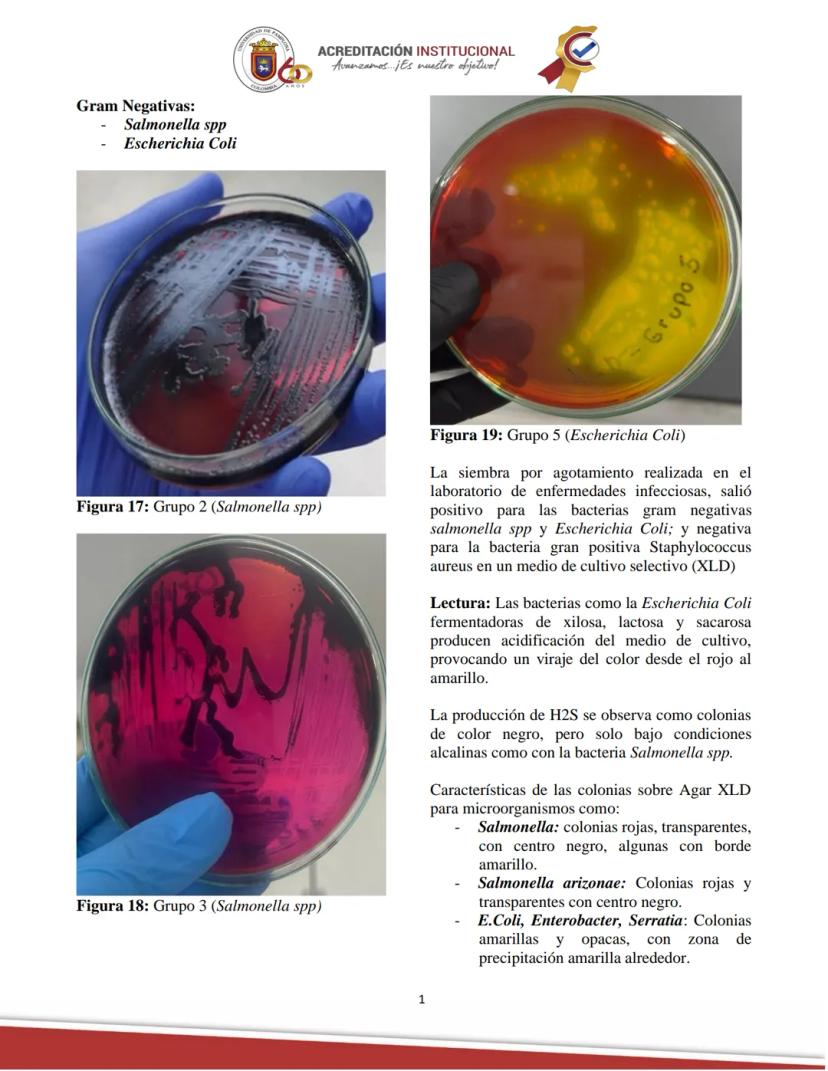
Page 16
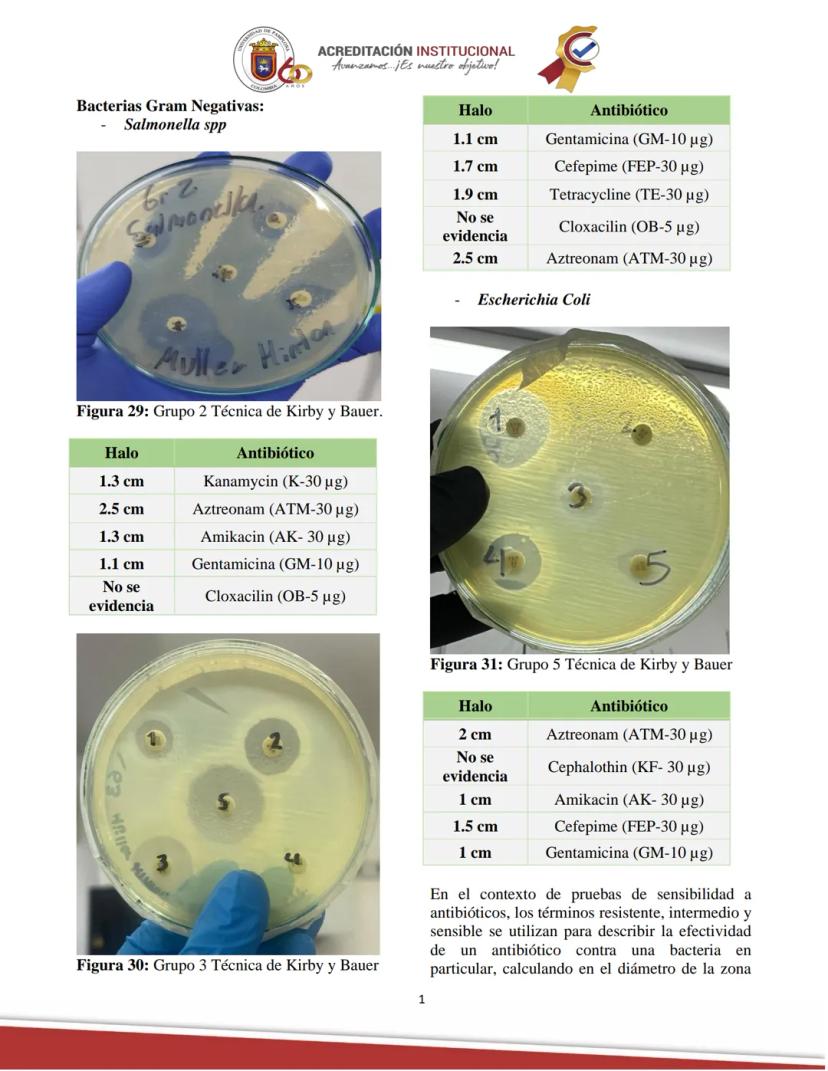
Page 20
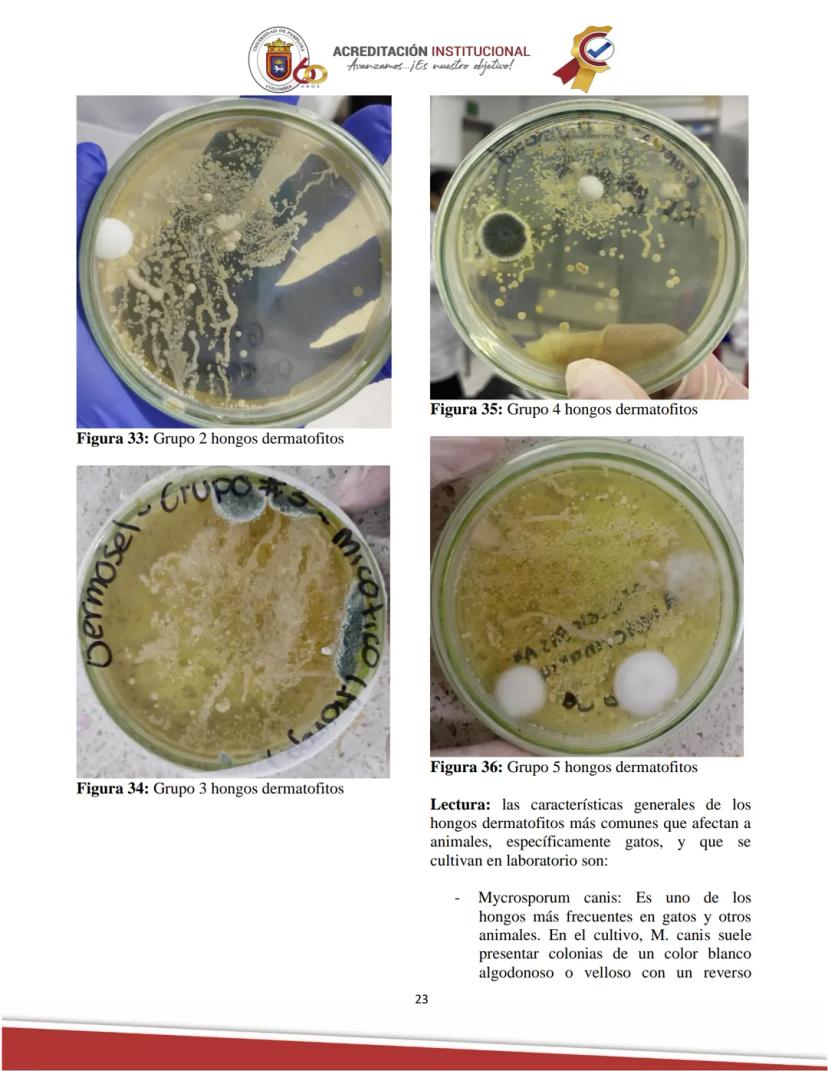
Page 23

El diagnóstico bacteriano de enfermedades infecciosas constituye una herramienta fundamental... Mostrar más
Guía de Microbiología Veterinaria: Medios de Cultivo y Resultados

Practica Nº 3: Diagnóstico Bacteriano
El diagnóstico bacteriano representa uno de los pilares fundamentales para el control de enfermedades infecciosas en medicina veterinaria. La correcta identificación de microorganismos patógenos permite establecer tratamientos efectivos y medidas de control adecuadas para proteger la salud animal y humana.
La Universidad de Pamplona, a través de la Facultad de Ciencias Agrarias y el Departamento de Medicina Veterinaria, desarrolla prácticas de laboratorio fundamentales para la formación de profesionales capaces de diagnosticar y tratar enfermedades infecciosas en animales.
Esta práctica específica, desarrollada por Camila Andrea Moreno Velásquez, explora las técnicas básicas de diagnóstico bacteriológico que todo médico veterinario debe dominar para su ejercicio profesional.
¡Dato clave! El diagnóstico bacteriológico no solo permite identificar al agente causal de una enfermedad, sino que también proporciona información vital sobre su sensibilidad a antibióticos, lo que guía la elección de tratamientos efectivos.

Diagnóstico Bacteriano de Enfermedades Infecciosas
El diagnóstico bacteriano constituye un pilar fundamental para combatir enfermedades infecciosas tanto en medicina veterinaria como humana. Esta práctica explora desde la obtención de muestras biológicas hasta la interpretación de resultados para establecer tratamientos efectivos.
El informe aborda la siembra de bacterias en medios de cultivo, un proceso que permite aislar e identificar patógenos a partir de muestras como orina, pus o secreciones. Se enfatiza que para estudiar correctamente una bacteria es necesario conocer tanto su morfología microscópica como macroscópica, esta última observable a través de las colonias bacterianas formadas en los medios de cultivo.
La técnica de siembra por agotamiento juega un papel crucial, permitiendo obtener colonias aisladas para su estudio. También se evalúa la sensibilidad a antibióticos mediante la colocación de discos en placas de agar y posterior observación de los halos de inhibición, lo que determina la efectividad de los diferentes fármacos contra el patógeno.
Adicionalmente, se incluye el estudio de hongos dermatofitos, ampliando el espectro de agentes infecciosos analizados. Todo este enfoque integral resulta esencial para establecer diagnósticos precisos y desarrollar estrategias de tratamiento adecuadas, contribuyendo significativamente a la erradicación de enfermedades infecciosas.
¡Recuerda! Las infecciones endógenas provienen de la microflora habitual del huésped, mientras que las exógenas son causadas por microorganismos del ambiente exterior.

Fundamentos Teóricos de las Infecciones
Las infecciones bacterianas ocurren cuando microorganismos patógenos invaden los tejidos del huésped y se multiplican, alterando el funcionamiento normal del organismo. Este proceso depende de factores como las características del microorganismo, la cantidad del inóculo y la respuesta inmune del huésped.
Existen dos tipos principales de infecciones según su origen: las endógenas, causadas por microorganismos de la propia microflora del paciente (predominantes en áreas desarrolladas), y las exógenas, provocadas por patógenos externos (más comunes en zonas de mayor pobreza). La flora endógena normalmente mantiene relaciones de comensalismo con el huésped, pero puede volverse patógena cuando se altera el equilibrio, especialmente en casos de compromiso inmunológico.
Las infecciones exógenas se transmiten por diversas vías, como la ruta fecal-oral, vía aérea, inoculación transcutánea, vía parenteral, sexual o mediante vectores artrópodos. Conocer estas rutas de transmisión resulta fundamental para establecer medidas eficaces de control y prevención.
El proceso de siembra bacteriana consiste en colocar las bacterias en medios de cultivo para su crecimiento y posterior análisis. Puede realizarse a partir de muestras biológicas o mediante subcultivos (repiques). El objetivo es obtener cultivos puros (axénicos) donde todas las células procedan de una misma célula original, permitiendo así su correcta identificación.
¡Punto importante! Las bacterias poseen una capacidad asombrosa para utilizar diversos compuestos nutritivos, desde moléculas inorgánicas sencillas hasta compuestos orgánicos complejos, lo que facilita su cultivo en laboratorio pero también su adaptabilidad en ambientes hostiles.

Medios de Cultivo en el Diagnóstico Bacteriológico
Los medios de cultivo son herramientas fundamentales en microbiología que cumplen diversos propósitos esenciales para el diagnóstico de enfermedades infecciosas. Permiten aislar bacterias de poblaciones mixtas, diferenciar grupos bacterianos relacionados, identificar microorganismos en diferentes muestras, evaluar el efecto de sustancias antimicrobianas y caracterizar microorganismos según sus capacidades metabólicas.
Medios Enriquecidos
Los medios enriquecidos están diseñados para favorecer el crecimiento de bacterias exigentes que requieren nutrientes específicos. Contienen componentes adicionales como suero sanguíneo o extractos de tejidos que proporcionan nutrientes esenciales. A diferencia de los medios selectivos, no inhiben el crecimiento de microorganismos no deseados.
El agar sangre es un ejemplo típico, que permite el crecimiento de la mayoría de las bacterias, incluso aquellas fastidiosas como Streptococcus pneumoniae. Este medio también ayuda a identificar características como la hemólisis (α, β o γ) producida por algunas bacterias. Otro ejemplo es el agar chocolate, que contiene sangre calentada para liberar factores de crecimiento como el NAD y la hemina.
Medios Selectivos
Los medios selectivos contienen sustancias que inhiben ciertos microorganismos mientras permiten el desarrollo de otros. Incluyen agentes como sales, colorantes o antibióticos que actúan como agentes selectivos. Son especialmente útiles para aislar patógenos específicos de muestras complejas.
El agar MacConkey es un medio selectivo para bacterias gramnegativas que contiene sales biliares y cristal violeta para inhibir bacterias grampositivas. Otro ejemplo es el agar manitol salado, cuya alta concentración de sal permite el crecimiento de estafilococos mientras inhibe otras bacterias.
¡Consejo práctico! Cuando trabajes con muestras clínicas complejas, siempre utiliza una combinación de medios selectivos y diferenciales para aumentar las probabilidades de aislar correctamente el patógeno de interés.

Medios Diferenciales e Identificación Bacteriana
Los medios diferenciales son fundamentales para distinguir entre especies bacterianas mediante reacciones bioquímicas visibles. Estos medios contienen indicadores que producen cambios de color o formación de precipitados cuando son metabolizados por ciertos microorganismos, permitiendo diferenciar colonias en muestras mixtas.
Estos medios destacan diferencias en características metabólicas como la capacidad para fermentar azúcares, producir enzimas o secretar productos específicos. El agar MacConkey, además de ser selectivo, es también diferencial, ya que distingue bacterias fermentadoras de lactosa (colonias rosadas) de las no fermentadoras (colonias incoloras). El agar eosina-azul de metileno (EMB) diferencia Escherichia coli (colonias con brillo metálico) de otras bacterias gramnegativas.
La identificación de bacterias hemolíticas se realiza utilizando agar sangre, que permite observar diferentes patrones de hemólisis alrededor de las colonias: β-hemólisis (halo claro), α-hemólisis (halo verdoso) o γ-hemólisis (ausencia de hemólisis). Para complementar la identificación, se realizan pruebas como la catalasa y la sensibilidad a bacitracina u optoquina.
Las enterobacterias, bacterias gramnegativas, se identifican mediante cultivos en medios selectivos y diferenciales como MacConkey y EMB, junto con pruebas bioquímicas como la producción de gas y ácido, prueba de ureasa y producción de H₂S. El sistema API 20E permite una caracterización más completa mediante pruebas bioquímicas miniaturizadas.
El diagnóstico de bacterias anaerobias requiere condiciones especiales de cultivo con baja o nula presencia de oxígeno. Se utilizan medios específicos como agar Schaedler o tioglicolato y sistemas de incubación anaeróbica. La identificación incluye pruebas como la catalasa, esporulación y métodos moleculares como PCR.
Para los estafilococos, se utiliza agar manitol salado y pruebas complementarias como la catalasa y la coagulasa, que permite diferenciar Staphylococcus aureus (coagulasa positivo) de otras especies como S. epidermidis (coagulasa negativo).
¡Dato importante! La combinación de varios métodos de identificación aumenta significativamente la precisión del diagnóstico bacteriológico, especialmente en casos de infecciones mixtas o con patógenos poco comunes.

Mecanismos de Acción y Resistencia a Antibióticos
Los antibióticos actúan contra las bacterias mediante diferentes mecanismos específicos. Los inhibidores de la síntesis de la pared celular, como penicilinas y cefalosporinas, interfieren con la formación de esta estructura vital, provocando la lisis bacteriana. Los inhibidores de la síntesis de proteínas, como aminoglucósidos, tetraciclinas y macrólidos, impiden la producción de proteínas esenciales uniéndose a los ribosomas.
Otros grupos importantes son los inhibidores de la síntesis de ácidos nucleicos (quinolonas y rifamicinas), los inhibidores de metabolitos (sulfonamidas y trimetoprim) que interfieren con la síntesis de ácido fólico, y los inhibidores de la membrana celular (polimixinas) que alteran la integridad de la membrana bacteriana.
Las bacterias han desarrollado diversos mecanismos para evadir la acción de los antibióticos. Las mutaciones genéticas espontáneas pueden alterar las proteínas diana del antibiótico, reduciendo su afinidad. La transferencia horizontal de genes mediante conjugación, transformación o transducción permite la propagación de resistencias entre bacterias.
Algunos mecanismos específicos incluyen la producción de enzimas que inactivan antibióticos, como las β-lactamasas que degradan penicilinas y cefalosporinas; el desarrollo de bombas de eflujo que expulsan activamente los antibióticos antes de que actúen; y la modificación del sitio de acción del antibiótico, alterando su estructura para que el fármaco ya no pueda unirse.
El uso excesivo e inadecuado de antibióticos en medicina humana y veterinaria ha acelerado el desarrollo y propagación de resistencias, constituyendo un grave problema de salud pública que requiere un enfoque prudente en su utilización.
¡Alerta! La resistencia a los antibióticos es un fenómeno natural acelerado por el mal uso de estos fármacos. Como futuros profesionales veterinarios, ustedes jugarán un papel crucial en el uso responsable de antibióticos para preservar su eficacia.

Diagnóstico de Tuberculosis Bovina
La tuberculosis bovina, causada por Mycobacterium bovis, representa una importante zoonosis que afecta tanto a la producción pecuaria como a la salud pública. El diagnóstico preciso de esta enfermedad es fundamental para implementar medidas eficaces de control y erradicación.
El artículo revisado describe los procedimientos para confirmar la tuberculosis en animales que han reaccionado a la prueba de tuberculina. Esta prueba cutánea, aunque valiosa como tamizaje inicial, puede presentar falsos positivos debido a reacciones cruzadas con otras micobacterias o a reacciones inespecíficas, lo que hace necesaria la confirmación mediante métodos de laboratorio más específicos.
El aislamiento bacteriológico constituye una técnica gold standard que consiste en obtener muestras de tejidos con lesiones sugestivas, procesarlas en condiciones de bioseguridad y cultivarlas en medios especializados como el Löwenstein-Jensen. Las colonias de M. bovis presentan un crecimiento lento y una morfología rugosa característica. Esta técnica, aunque definitiva, requiere tiempo y recursos considerables.
El análisis histopatológico complementa el diagnóstico mediante la observación microscópica de cortes de tejido teñidos con hematoxilina-eosina y Ziehl-Neelsen. Se buscan granulomas típicos con células epitelioides, linfocitos y células gigantes de Langhans, así como la presencia de bacilos ácido-alcohol resistentes que confirman la sospecha.
El artículo enfatiza la importancia de un enfoque integrado, combinando ambas técnicas para asegurar diagnósticos precisos, reducir falsos positivos y mejorar las estrategias de control. Este enfoque riguroso es esencial para apoyar los programas de erradicación y proteger tanto la salud animal como la humana.
¡Reflexión importante! La tuberculosis bovina ejemplifica perfectamente el concepto "Una Salud", donde la sanidad animal y humana están intrínsecamente conectadas. Un diagnóstico preciso no solo protege al ganado, sino también a las personas que trabajan con estos animales o consumen sus productos.

Materiales, Métodos y Técnicas de Tinción
El diagnóstico microbiológico requiere equipos y materiales específicos para obtener resultados confiables. En esta práctica se utilizaron asas microbiológicas, mechero Bunsen, pinzas, cultivos de diversos microorganismos, portaobjetos, microscopio, aceite de inmersión y muestras de hongo dermatofito. Entre los reactivos empleados destacan diferentes tipos de agar (MacConkey, SS, XLD, Manitol Salado, Müller Hinton), caldos nutritivos y los necesarios para la tinción de Gram .
La tinción de Gram constituye una técnica fundamental para la clasificación inicial de bacterias. El procedimiento comienza con la preparación de un extendido delgado de la muestra bacteriana en un portaobjeto, que se fija con calor. Luego se aplica cristal violeta durante 1 minuto, se lava con agua y se cubre con solución de yodo por otro minuto. La decoloración con alcohol-acetona es crucial, pues determina si las bacterias retendrán el colorante primario. Finalmente, se aplica safranina como colorante de contraste y se observa al microscopio con objetivo 100X utilizando aceite de inmersión.
Las bacterias Gram positivas retienen el complejo cristal violeta-yodo debido a su gruesa pared de peptidoglicano, apareciendo moradas. Las Gram negativas, con pared más delgada y una membrana externa adicional, se decoloran con el alcohol y toman el color rosa de la safranina. Esta diferencia fundamental ayuda a dirigir el diagnóstico y el tratamiento, ya que refleja diferencias estructurales importantes entre estos dos grandes grupos bacterianos.
La siembra por agotamiento en medios sólidos permite obtener colonias aisladas. Se realiza calentando el asa de siembra, enfriándola brevemente, tomando una muestra del cultivo bacteriano y sembrando en estrías sobre el agar nuevo. Las placas se incuban invertidas a 37°C para favorecer el crecimiento bacteriano.
¡Ojo con esto! En la tinción de Gram, el tiempo de decoloración con alcohol es crítico: si es excesivo, algunas bacterias Gram positivas pueden aparecer como Gram negativas; si es insuficiente, bacterias Gram negativas pueden retener el cristal violeta y dar falsos positivos.

Técnicas de Siembra y Antibiograma
La siembra masiva para antibiograma requiere un protocolo específico que garantice resultados confiables. Primero, se toma una muestra bacteriana con un hisopo estéril de la placa de cultivo original. Esta muestra se transfiere a un tubo con caldo nutritivo, mezclando bien hasta obtener una turbidez óptima que indica una concentración adecuada de bacterias.
Con el hisopo impregnado de esta suspensión bacteriana, se realiza una siembra masiva sobre toda la superficie de una placa de agar Müller Hinton, cubriendo completamente el medio en varias direcciones. Esta técnica asegura una distribución uniforme de las bacterias, fundamental para la correcta interpretación de los resultados del antibiograma.
Después de la siembra, se colocan discos impregnados con diferentes antibióticos utilizando pinzas estériles. Estos discos deben distribuirse estratégicamente para que los halos de inhibición no se superpongan. Finalmente, la placa se sella, etiqueta e incuba a 37°C, temperatura óptima para el crecimiento bacteriano.
Para el cultivo de hongos dermatofitos, se utilizó una técnica específica adaptada a sus requerimientos de crecimiento. Se obtuvieron pelos y escamas de piel de un gato con sospecha de infección fúngica. Con un asa estéril, pequeñas porciones de este material se colocaron sobre la superficie de un agar nutritivo específico para dermatofitos.
A diferencia de las bacterias, los hongos requieren periodos de incubación más largos y temperaturas diferentes. En este caso, las placas se incubaron a 25°C durante 7 días, permitiendo el desarrollo adecuado de las colonias fúngicas para su posterior observación y análisis. Esta diferencia en las condiciones de cultivo refleja los distintos requerimientos metabólicos entre bacterias y hongos.
¡Consejo práctico! Al realizar un antibiograma, la densidad del inóculo es crucial: si es muy densa, puede dar falsos resultados de resistencia; si es muy diluida, puede mostrar falsa sensibilidad. Siempre ajusta la turbidez según los estándares McFarland.

Resultados de la Tinción de Gram
Los resultados de la tinción de Gram revelaron características morfológicas distintivas de las tres bacterias analizadas en el laboratorio. El Staphylococcus aureus se observó como cocos Gram positivos agrupados en racimos característicos, apareciendo de color púrpura o violeta al microscopio. Esta coloración se debe a que su gruesa pared de peptidoglicano retiene el complejo cristal violeta-yodo durante la decoloración.
La Salmonella spp. debería haberse observado como bacilos Gram negativos de color rosado, sin embargo, se detectó un error técnico en algunas preparaciones donde apareció de color púrpura. Este error probablemente se debió a una decoloración insuficiente con alcohol-acetona, lo que permitió que estas bacterias Gram negativas retuvieran el colorante primario, dando un falso resultado positivo.
La Escherichia coli se visualizó correctamente como bacilos Gram negativos de color rosado. Estas bacterias tienen una pared celular delgada con pocas capas de peptidoglicano y una membrana externa adicional, lo que hace que pierdan el cristal violeta durante la decoloración y se tiñan con la safranina.
Las bacterias Gram positivas, como S. aureus, poseen una pared celular gruesa compuesta principalmente por múltiples capas de peptidoglicano que contiene ácidos teicoicos. Esta estructura densa impide que el complejo cristal violeta-yodo se elimine durante la decoloración. En contraste, las bacterias Gram negativas, como E. coli y Salmonella, tienen una pared celular delgada y una membrana externa compuesta por lipopolisacáridos que las hace más resistentes a ciertos antibióticos.
La tinción de Gram constituye un primer paso crítico en la identificación bacteriana, orientando la selección de medios de cultivo y pruebas adicionales para un diagnóstico definitivo.
¡Importante! Si observas resultados inesperados en la tinción de Gram, como bacterias con coloración inconsistente con su clasificación conocida, revisa aspectos técnicos como el tiempo de decoloración, la antigüedad de los reactivos o el grosor de la preparación antes de cuestionar la identidad de la bacteria.



















Pensamos que nunca lo preguntarías...
¿Qué es Knowunity AI companion?
Nuestro compañero de IA está específicamente adaptado a las necesidades de los estudiantes. Basándonos en los millones de contenidos que tenemos en la plataforma, podemos dar a los estudiantes respuestas realmente significativas y relevantes. Pero no se trata solo de respuestas, el compañero también guía a los estudiantes a través de sus retos de aprendizaje diarios, con planes de aprendizaje personalizados, cuestionarios o contenidos en el chat y una personalización del 100% basada en las habilidades y el desarrollo de los estudiantes.
¿Dónde puedo descargar la app Knowunity?
Puedes descargar la app en Google Play Store y Apple App Store.
¿Knowunity es totalmente gratuito?
¡Sí lo es! Tienes acceso totalmente gratuito a todo el contenido de la app, puedes chatear con otros alumnos y recibir ayuda inmeditamente. Puedes ganar dinero utilizando la aplicación, que te permitirá acceder a determinadas funciones.
Contenidos más populares de Química
9Contenidos más populares
9¿No encuentras lo que buscas? Explora otros temas.
Mira lo que dicen nuestros usuarios. Les encantó — y a ti también te encantará.
La app es muy fácil de usar y está muy bien diseñada. Hasta ahora he encontrado todo lo que estaba buscando y he podido aprender mucho de las presentaciones. Definitivamente utilizaré la aplicación para un examen de clase. Y, por supuesto, también me sirve mucho de inspiración.
Esta app es realmente genial. Hay tantos apuntes de clase y ayuda [...]. Tengo problemas con matemáticas, por ejemplo, y la aplicación tiene muchas opciones de ayuda. Gracias a Knowunity, he mejorado en mates. Se la recomiendo a todo el mundo.
Vaya, estoy realmente sorprendida. Acabo de probar la app porque la he visto anunciada muchas veces y me he quedado absolutamente alucinada. Esta app es LA AYUDA que quieres para el insti y, sobre todo, ofrece muchísimas cosas, como ejercicios y hojas informativas, que a mí personalmente me han sido MUY útiles.
Guía de Microbiología Veterinaria: Medios de Cultivo y Resultados
El diagnóstico bacteriano de enfermedades infecciosas constituye una herramienta fundamental en medicina veterinaria. Esta práctica aborda los métodos de identificación, cultivo y evaluación de la sensibilidad a antibióticos de diversos microorganismos patógenos, un proceso esencial para establecer tratamientos efectivos y... Mostrar más

Inscríbete para ver los apuntes. ¡Es gratis!
- Acceso a todos los documentos
- Mejora tus notas
- Únete a millones de estudiantes
Practica Nº 3: Diagnóstico Bacteriano
El diagnóstico bacteriano representa uno de los pilares fundamentales para el control de enfermedades infecciosas en medicina veterinaria. La correcta identificación de microorganismos patógenos permite establecer tratamientos efectivos y medidas de control adecuadas para proteger la salud animal y humana.
La Universidad de Pamplona, a través de la Facultad de Ciencias Agrarias y el Departamento de Medicina Veterinaria, desarrolla prácticas de laboratorio fundamentales para la formación de profesionales capaces de diagnosticar y tratar enfermedades infecciosas en animales.
Esta práctica específica, desarrollada por Camila Andrea Moreno Velásquez, explora las técnicas básicas de diagnóstico bacteriológico que todo médico veterinario debe dominar para su ejercicio profesional.
¡Dato clave! El diagnóstico bacteriológico no solo permite identificar al agente causal de una enfermedad, sino que también proporciona información vital sobre su sensibilidad a antibióticos, lo que guía la elección de tratamientos efectivos.

Inscríbete para ver los apuntes. ¡Es gratis!
- Acceso a todos los documentos
- Mejora tus notas
- Únete a millones de estudiantes
Diagnóstico Bacteriano de Enfermedades Infecciosas
El diagnóstico bacteriano constituye un pilar fundamental para combatir enfermedades infecciosas tanto en medicina veterinaria como humana. Esta práctica explora desde la obtención de muestras biológicas hasta la interpretación de resultados para establecer tratamientos efectivos.
El informe aborda la siembra de bacterias en medios de cultivo, un proceso que permite aislar e identificar patógenos a partir de muestras como orina, pus o secreciones. Se enfatiza que para estudiar correctamente una bacteria es necesario conocer tanto su morfología microscópica como macroscópica, esta última observable a través de las colonias bacterianas formadas en los medios de cultivo.
La técnica de siembra por agotamiento juega un papel crucial, permitiendo obtener colonias aisladas para su estudio. También se evalúa la sensibilidad a antibióticos mediante la colocación de discos en placas de agar y posterior observación de los halos de inhibición, lo que determina la efectividad de los diferentes fármacos contra el patógeno.
Adicionalmente, se incluye el estudio de hongos dermatofitos, ampliando el espectro de agentes infecciosos analizados. Todo este enfoque integral resulta esencial para establecer diagnósticos precisos y desarrollar estrategias de tratamiento adecuadas, contribuyendo significativamente a la erradicación de enfermedades infecciosas.
¡Recuerda! Las infecciones endógenas provienen de la microflora habitual del huésped, mientras que las exógenas son causadas por microorganismos del ambiente exterior.

Inscríbete para ver los apuntes. ¡Es gratis!
- Acceso a todos los documentos
- Mejora tus notas
- Únete a millones de estudiantes
Fundamentos Teóricos de las Infecciones
Las infecciones bacterianas ocurren cuando microorganismos patógenos invaden los tejidos del huésped y se multiplican, alterando el funcionamiento normal del organismo. Este proceso depende de factores como las características del microorganismo, la cantidad del inóculo y la respuesta inmune del huésped.
Existen dos tipos principales de infecciones según su origen: las endógenas, causadas por microorganismos de la propia microflora del paciente (predominantes en áreas desarrolladas), y las exógenas, provocadas por patógenos externos (más comunes en zonas de mayor pobreza). La flora endógena normalmente mantiene relaciones de comensalismo con el huésped, pero puede volverse patógena cuando se altera el equilibrio, especialmente en casos de compromiso inmunológico.
Las infecciones exógenas se transmiten por diversas vías, como la ruta fecal-oral, vía aérea, inoculación transcutánea, vía parenteral, sexual o mediante vectores artrópodos. Conocer estas rutas de transmisión resulta fundamental para establecer medidas eficaces de control y prevención.
El proceso de siembra bacteriana consiste en colocar las bacterias en medios de cultivo para su crecimiento y posterior análisis. Puede realizarse a partir de muestras biológicas o mediante subcultivos (repiques). El objetivo es obtener cultivos puros (axénicos) donde todas las células procedan de una misma célula original, permitiendo así su correcta identificación.
¡Punto importante! Las bacterias poseen una capacidad asombrosa para utilizar diversos compuestos nutritivos, desde moléculas inorgánicas sencillas hasta compuestos orgánicos complejos, lo que facilita su cultivo en laboratorio pero también su adaptabilidad en ambientes hostiles.

Inscríbete para ver los apuntes. ¡Es gratis!
- Acceso a todos los documentos
- Mejora tus notas
- Únete a millones de estudiantes
Medios de Cultivo en el Diagnóstico Bacteriológico
Los medios de cultivo son herramientas fundamentales en microbiología que cumplen diversos propósitos esenciales para el diagnóstico de enfermedades infecciosas. Permiten aislar bacterias de poblaciones mixtas, diferenciar grupos bacterianos relacionados, identificar microorganismos en diferentes muestras, evaluar el efecto de sustancias antimicrobianas y caracterizar microorganismos según sus capacidades metabólicas.
Medios Enriquecidos
Los medios enriquecidos están diseñados para favorecer el crecimiento de bacterias exigentes que requieren nutrientes específicos. Contienen componentes adicionales como suero sanguíneo o extractos de tejidos que proporcionan nutrientes esenciales. A diferencia de los medios selectivos, no inhiben el crecimiento de microorganismos no deseados.
El agar sangre es un ejemplo típico, que permite el crecimiento de la mayoría de las bacterias, incluso aquellas fastidiosas como Streptococcus pneumoniae. Este medio también ayuda a identificar características como la hemólisis (α, β o γ) producida por algunas bacterias. Otro ejemplo es el agar chocolate, que contiene sangre calentada para liberar factores de crecimiento como el NAD y la hemina.
Medios Selectivos
Los medios selectivos contienen sustancias que inhiben ciertos microorganismos mientras permiten el desarrollo de otros. Incluyen agentes como sales, colorantes o antibióticos que actúan como agentes selectivos. Son especialmente útiles para aislar patógenos específicos de muestras complejas.
El agar MacConkey es un medio selectivo para bacterias gramnegativas que contiene sales biliares y cristal violeta para inhibir bacterias grampositivas. Otro ejemplo es el agar manitol salado, cuya alta concentración de sal permite el crecimiento de estafilococos mientras inhibe otras bacterias.
¡Consejo práctico! Cuando trabajes con muestras clínicas complejas, siempre utiliza una combinación de medios selectivos y diferenciales para aumentar las probabilidades de aislar correctamente el patógeno de interés.

Inscríbete para ver los apuntes. ¡Es gratis!
- Acceso a todos los documentos
- Mejora tus notas
- Únete a millones de estudiantes
Medios Diferenciales e Identificación Bacteriana
Los medios diferenciales son fundamentales para distinguir entre especies bacterianas mediante reacciones bioquímicas visibles. Estos medios contienen indicadores que producen cambios de color o formación de precipitados cuando son metabolizados por ciertos microorganismos, permitiendo diferenciar colonias en muestras mixtas.
Estos medios destacan diferencias en características metabólicas como la capacidad para fermentar azúcares, producir enzimas o secretar productos específicos. El agar MacConkey, además de ser selectivo, es también diferencial, ya que distingue bacterias fermentadoras de lactosa (colonias rosadas) de las no fermentadoras (colonias incoloras). El agar eosina-azul de metileno (EMB) diferencia Escherichia coli (colonias con brillo metálico) de otras bacterias gramnegativas.
La identificación de bacterias hemolíticas se realiza utilizando agar sangre, que permite observar diferentes patrones de hemólisis alrededor de las colonias: β-hemólisis (halo claro), α-hemólisis (halo verdoso) o γ-hemólisis (ausencia de hemólisis). Para complementar la identificación, se realizan pruebas como la catalasa y la sensibilidad a bacitracina u optoquina.
Las enterobacterias, bacterias gramnegativas, se identifican mediante cultivos en medios selectivos y diferenciales como MacConkey y EMB, junto con pruebas bioquímicas como la producción de gas y ácido, prueba de ureasa y producción de H₂S. El sistema API 20E permite una caracterización más completa mediante pruebas bioquímicas miniaturizadas.
El diagnóstico de bacterias anaerobias requiere condiciones especiales de cultivo con baja o nula presencia de oxígeno. Se utilizan medios específicos como agar Schaedler o tioglicolato y sistemas de incubación anaeróbica. La identificación incluye pruebas como la catalasa, esporulación y métodos moleculares como PCR.
Para los estafilococos, se utiliza agar manitol salado y pruebas complementarias como la catalasa y la coagulasa, que permite diferenciar Staphylococcus aureus (coagulasa positivo) de otras especies como S. epidermidis (coagulasa negativo).
¡Dato importante! La combinación de varios métodos de identificación aumenta significativamente la precisión del diagnóstico bacteriológico, especialmente en casos de infecciones mixtas o con patógenos poco comunes.

Inscríbete para ver los apuntes. ¡Es gratis!
- Acceso a todos los documentos
- Mejora tus notas
- Únete a millones de estudiantes
Mecanismos de Acción y Resistencia a Antibióticos
Los antibióticos actúan contra las bacterias mediante diferentes mecanismos específicos. Los inhibidores de la síntesis de la pared celular, como penicilinas y cefalosporinas, interfieren con la formación de esta estructura vital, provocando la lisis bacteriana. Los inhibidores de la síntesis de proteínas, como aminoglucósidos, tetraciclinas y macrólidos, impiden la producción de proteínas esenciales uniéndose a los ribosomas.
Otros grupos importantes son los inhibidores de la síntesis de ácidos nucleicos (quinolonas y rifamicinas), los inhibidores de metabolitos (sulfonamidas y trimetoprim) que interfieren con la síntesis de ácido fólico, y los inhibidores de la membrana celular (polimixinas) que alteran la integridad de la membrana bacteriana.
Las bacterias han desarrollado diversos mecanismos para evadir la acción de los antibióticos. Las mutaciones genéticas espontáneas pueden alterar las proteínas diana del antibiótico, reduciendo su afinidad. La transferencia horizontal de genes mediante conjugación, transformación o transducción permite la propagación de resistencias entre bacterias.
Algunos mecanismos específicos incluyen la producción de enzimas que inactivan antibióticos, como las β-lactamasas que degradan penicilinas y cefalosporinas; el desarrollo de bombas de eflujo que expulsan activamente los antibióticos antes de que actúen; y la modificación del sitio de acción del antibiótico, alterando su estructura para que el fármaco ya no pueda unirse.
El uso excesivo e inadecuado de antibióticos en medicina humana y veterinaria ha acelerado el desarrollo y propagación de resistencias, constituyendo un grave problema de salud pública que requiere un enfoque prudente en su utilización.
¡Alerta! La resistencia a los antibióticos es un fenómeno natural acelerado por el mal uso de estos fármacos. Como futuros profesionales veterinarios, ustedes jugarán un papel crucial en el uso responsable de antibióticos para preservar su eficacia.

Inscríbete para ver los apuntes. ¡Es gratis!
- Acceso a todos los documentos
- Mejora tus notas
- Únete a millones de estudiantes
Diagnóstico de Tuberculosis Bovina
La tuberculosis bovina, causada por Mycobacterium bovis, representa una importante zoonosis que afecta tanto a la producción pecuaria como a la salud pública. El diagnóstico preciso de esta enfermedad es fundamental para implementar medidas eficaces de control y erradicación.
El artículo revisado describe los procedimientos para confirmar la tuberculosis en animales que han reaccionado a la prueba de tuberculina. Esta prueba cutánea, aunque valiosa como tamizaje inicial, puede presentar falsos positivos debido a reacciones cruzadas con otras micobacterias o a reacciones inespecíficas, lo que hace necesaria la confirmación mediante métodos de laboratorio más específicos.
El aislamiento bacteriológico constituye una técnica gold standard que consiste en obtener muestras de tejidos con lesiones sugestivas, procesarlas en condiciones de bioseguridad y cultivarlas en medios especializados como el Löwenstein-Jensen. Las colonias de M. bovis presentan un crecimiento lento y una morfología rugosa característica. Esta técnica, aunque definitiva, requiere tiempo y recursos considerables.
El análisis histopatológico complementa el diagnóstico mediante la observación microscópica de cortes de tejido teñidos con hematoxilina-eosina y Ziehl-Neelsen. Se buscan granulomas típicos con células epitelioides, linfocitos y células gigantes de Langhans, así como la presencia de bacilos ácido-alcohol resistentes que confirman la sospecha.
El artículo enfatiza la importancia de un enfoque integrado, combinando ambas técnicas para asegurar diagnósticos precisos, reducir falsos positivos y mejorar las estrategias de control. Este enfoque riguroso es esencial para apoyar los programas de erradicación y proteger tanto la salud animal como la humana.
¡Reflexión importante! La tuberculosis bovina ejemplifica perfectamente el concepto "Una Salud", donde la sanidad animal y humana están intrínsecamente conectadas. Un diagnóstico preciso no solo protege al ganado, sino también a las personas que trabajan con estos animales o consumen sus productos.

Inscríbete para ver los apuntes. ¡Es gratis!
- Acceso a todos los documentos
- Mejora tus notas
- Únete a millones de estudiantes
Materiales, Métodos y Técnicas de Tinción
El diagnóstico microbiológico requiere equipos y materiales específicos para obtener resultados confiables. En esta práctica se utilizaron asas microbiológicas, mechero Bunsen, pinzas, cultivos de diversos microorganismos, portaobjetos, microscopio, aceite de inmersión y muestras de hongo dermatofito. Entre los reactivos empleados destacan diferentes tipos de agar (MacConkey, SS, XLD, Manitol Salado, Müller Hinton), caldos nutritivos y los necesarios para la tinción de Gram .
La tinción de Gram constituye una técnica fundamental para la clasificación inicial de bacterias. El procedimiento comienza con la preparación de un extendido delgado de la muestra bacteriana en un portaobjeto, que se fija con calor. Luego se aplica cristal violeta durante 1 minuto, se lava con agua y se cubre con solución de yodo por otro minuto. La decoloración con alcohol-acetona es crucial, pues determina si las bacterias retendrán el colorante primario. Finalmente, se aplica safranina como colorante de contraste y se observa al microscopio con objetivo 100X utilizando aceite de inmersión.
Las bacterias Gram positivas retienen el complejo cristal violeta-yodo debido a su gruesa pared de peptidoglicano, apareciendo moradas. Las Gram negativas, con pared más delgada y una membrana externa adicional, se decoloran con el alcohol y toman el color rosa de la safranina. Esta diferencia fundamental ayuda a dirigir el diagnóstico y el tratamiento, ya que refleja diferencias estructurales importantes entre estos dos grandes grupos bacterianos.
La siembra por agotamiento en medios sólidos permite obtener colonias aisladas. Se realiza calentando el asa de siembra, enfriándola brevemente, tomando una muestra del cultivo bacteriano y sembrando en estrías sobre el agar nuevo. Las placas se incuban invertidas a 37°C para favorecer el crecimiento bacteriano.
¡Ojo con esto! En la tinción de Gram, el tiempo de decoloración con alcohol es crítico: si es excesivo, algunas bacterias Gram positivas pueden aparecer como Gram negativas; si es insuficiente, bacterias Gram negativas pueden retener el cristal violeta y dar falsos positivos.

Inscríbete para ver los apuntes. ¡Es gratis!
- Acceso a todos los documentos
- Mejora tus notas
- Únete a millones de estudiantes
Técnicas de Siembra y Antibiograma
La siembra masiva para antibiograma requiere un protocolo específico que garantice resultados confiables. Primero, se toma una muestra bacteriana con un hisopo estéril de la placa de cultivo original. Esta muestra se transfiere a un tubo con caldo nutritivo, mezclando bien hasta obtener una turbidez óptima que indica una concentración adecuada de bacterias.
Con el hisopo impregnado de esta suspensión bacteriana, se realiza una siembra masiva sobre toda la superficie de una placa de agar Müller Hinton, cubriendo completamente el medio en varias direcciones. Esta técnica asegura una distribución uniforme de las bacterias, fundamental para la correcta interpretación de los resultados del antibiograma.
Después de la siembra, se colocan discos impregnados con diferentes antibióticos utilizando pinzas estériles. Estos discos deben distribuirse estratégicamente para que los halos de inhibición no se superpongan. Finalmente, la placa se sella, etiqueta e incuba a 37°C, temperatura óptima para el crecimiento bacteriano.
Para el cultivo de hongos dermatofitos, se utilizó una técnica específica adaptada a sus requerimientos de crecimiento. Se obtuvieron pelos y escamas de piel de un gato con sospecha de infección fúngica. Con un asa estéril, pequeñas porciones de este material se colocaron sobre la superficie de un agar nutritivo específico para dermatofitos.
A diferencia de las bacterias, los hongos requieren periodos de incubación más largos y temperaturas diferentes. En este caso, las placas se incubaron a 25°C durante 7 días, permitiendo el desarrollo adecuado de las colonias fúngicas para su posterior observación y análisis. Esta diferencia en las condiciones de cultivo refleja los distintos requerimientos metabólicos entre bacterias y hongos.
¡Consejo práctico! Al realizar un antibiograma, la densidad del inóculo es crucial: si es muy densa, puede dar falsos resultados de resistencia; si es muy diluida, puede mostrar falsa sensibilidad. Siempre ajusta la turbidez según los estándares McFarland.

Inscríbete para ver los apuntes. ¡Es gratis!
- Acceso a todos los documentos
- Mejora tus notas
- Únete a millones de estudiantes
Resultados de la Tinción de Gram
Los resultados de la tinción de Gram revelaron características morfológicas distintivas de las tres bacterias analizadas en el laboratorio. El Staphylococcus aureus se observó como cocos Gram positivos agrupados en racimos característicos, apareciendo de color púrpura o violeta al microscopio. Esta coloración se debe a que su gruesa pared de peptidoglicano retiene el complejo cristal violeta-yodo durante la decoloración.
La Salmonella spp. debería haberse observado como bacilos Gram negativos de color rosado, sin embargo, se detectó un error técnico en algunas preparaciones donde apareció de color púrpura. Este error probablemente se debió a una decoloración insuficiente con alcohol-acetona, lo que permitió que estas bacterias Gram negativas retuvieran el colorante primario, dando un falso resultado positivo.
La Escherichia coli se visualizó correctamente como bacilos Gram negativos de color rosado. Estas bacterias tienen una pared celular delgada con pocas capas de peptidoglicano y una membrana externa adicional, lo que hace que pierdan el cristal violeta durante la decoloración y se tiñan con la safranina.
Las bacterias Gram positivas, como S. aureus, poseen una pared celular gruesa compuesta principalmente por múltiples capas de peptidoglicano que contiene ácidos teicoicos. Esta estructura densa impide que el complejo cristal violeta-yodo se elimine durante la decoloración. En contraste, las bacterias Gram negativas, como E. coli y Salmonella, tienen una pared celular delgada y una membrana externa compuesta por lipopolisacáridos que las hace más resistentes a ciertos antibióticos.
La tinción de Gram constituye un primer paso crítico en la identificación bacteriana, orientando la selección de medios de cultivo y pruebas adicionales para un diagnóstico definitivo.
¡Importante! Si observas resultados inesperados en la tinción de Gram, como bacterias con coloración inconsistente con su clasificación conocida, revisa aspectos técnicos como el tiempo de decoloración, la antigüedad de los reactivos o el grosor de la preparación antes de cuestionar la identidad de la bacteria.

Inscríbete para ver los apuntes. ¡Es gratis!
- Acceso a todos los documentos
- Mejora tus notas
- Únete a millones de estudiantes

Inscríbete para ver los apuntes. ¡Es gratis!
- Acceso a todos los documentos
- Mejora tus notas
- Únete a millones de estudiantes

Inscríbete para ver los apuntes. ¡Es gratis!
- Acceso a todos los documentos
- Mejora tus notas
- Únete a millones de estudiantes

Inscríbete para ver los apuntes. ¡Es gratis!
- Acceso a todos los documentos
- Mejora tus notas
- Únete a millones de estudiantes

Inscríbete para ver los apuntes. ¡Es gratis!
- Acceso a todos los documentos
- Mejora tus notas
- Únete a millones de estudiantes

Inscríbete para ver los apuntes. ¡Es gratis!
- Acceso a todos los documentos
- Mejora tus notas
- Únete a millones de estudiantes

Inscríbete para ver los apuntes. ¡Es gratis!
- Acceso a todos los documentos
- Mejora tus notas
- Únete a millones de estudiantes

Inscríbete para ver los apuntes. ¡Es gratis!
- Acceso a todos los documentos
- Mejora tus notas
- Únete a millones de estudiantes

Inscríbete para ver los apuntes. ¡Es gratis!
- Acceso a todos los documentos
- Mejora tus notas
- Únete a millones de estudiantes

Inscríbete para ver los apuntes. ¡Es gratis!
- Acceso a todos los documentos
- Mejora tus notas
- Únete a millones de estudiantes

Inscríbete para ver los apuntes. ¡Es gratis!
- Acceso a todos los documentos
- Mejora tus notas
- Únete a millones de estudiantes

Inscríbete para ver los apuntes. ¡Es gratis!
- Acceso a todos los documentos
- Mejora tus notas
- Únete a millones de estudiantes

Inscríbete para ver los apuntes. ¡Es gratis!
- Acceso a todos los documentos
- Mejora tus notas
- Únete a millones de estudiantes

Inscríbete para ver los apuntes. ¡Es gratis!
- Acceso a todos los documentos
- Mejora tus notas
- Únete a millones de estudiantes

Inscríbete para ver los apuntes. ¡Es gratis!
- Acceso a todos los documentos
- Mejora tus notas
- Únete a millones de estudiantes

Inscríbete para ver los apuntes. ¡Es gratis!
- Acceso a todos los documentos
- Mejora tus notas
- Únete a millones de estudiantes

Inscríbete para ver los apuntes. ¡Es gratis!
- Acceso a todos los documentos
- Mejora tus notas
- Únete a millones de estudiantes

Inscríbete para ver los apuntes. ¡Es gratis!
- Acceso a todos los documentos
- Mejora tus notas
- Únete a millones de estudiantes

Inscríbete para ver los apuntes. ¡Es gratis!
- Acceso a todos los documentos
- Mejora tus notas
- Únete a millones de estudiantes
Pensamos que nunca lo preguntarías...
¿Qué es Knowunity AI companion?
Nuestro compañero de IA está específicamente adaptado a las necesidades de los estudiantes. Basándonos en los millones de contenidos que tenemos en la plataforma, podemos dar a los estudiantes respuestas realmente significativas y relevantes. Pero no se trata solo de respuestas, el compañero también guía a los estudiantes a través de sus retos de aprendizaje diarios, con planes de aprendizaje personalizados, cuestionarios o contenidos en el chat y una personalización del 100% basada en las habilidades y el desarrollo de los estudiantes.
¿Dónde puedo descargar la app Knowunity?
Puedes descargar la app en Google Play Store y Apple App Store.
¿Knowunity es totalmente gratuito?
¡Sí lo es! Tienes acceso totalmente gratuito a todo el contenido de la app, puedes chatear con otros alumnos y recibir ayuda inmeditamente. Puedes ganar dinero utilizando la aplicación, que te permitirá acceder a determinadas funciones.
Contenidos más populares de Química
9Contenidos más populares
9¿No encuentras lo que buscas? Explora otros temas.
Mira lo que dicen nuestros usuarios. Les encantó — y a ti también te encantará.
La app es muy fácil de usar y está muy bien diseñada. Hasta ahora he encontrado todo lo que estaba buscando y he podido aprender mucho de las presentaciones. Definitivamente utilizaré la aplicación para un examen de clase. Y, por supuesto, también me sirve mucho de inspiración.
Esta app es realmente genial. Hay tantos apuntes de clase y ayuda [...]. Tengo problemas con matemáticas, por ejemplo, y la aplicación tiene muchas opciones de ayuda. Gracias a Knowunity, he mejorado en mates. Se la recomiendo a todo el mundo.
Vaya, estoy realmente sorprendida. Acabo de probar la app porque la he visto anunciada muchas veces y me he quedado absolutamente alucinada. Esta app es LA AYUDA que quieres para el insti y, sobre todo, ofrece muchísimas cosas, como ejercicios y hojas informativas, que a mí personalmente me han sido MUY útiles.